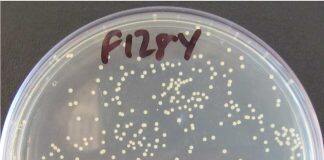
MRSA enzyme could help tackle antibiotic tolerance timebomb

About United Kingdom Education News, Study in United Kingdom, Education in United Kingdom, United Kingdom University, University News, University Ranking, Study Abroad, Online Education, Education News, Education Fairs, Job Opportunities, Graduate Program, Undergraduate Programs, Admissions, etc…
Tag: United Kingdom News
Put ChatGPT in C-3PO to make AI as intelligent as humans,...
Connecting multiple AIs together and putting them in the body of a robot, similar to Star Wars’ C-3PO or R2-D2, is the most likely way AI will become as intelligent as humans, according to a scientist from the University of Sheffield.
‘Squishy’ lasers could reveal how tumours and babies grow
New ‘squishy’ lasers could help solve the mystery of the biological forces that control the development of embryos and cancerous tumours.
University of Sheffield academics given highest honour by British Academy
Three academics from the University of Sheffield have been elected Fellows of the British Academy - the highest honour bestowed by the UK’s national academy for the humanities and social sciences.
MRSA enzyme could help tackle antibiotic tolerance timebomb
Scientists at the University of St Andrews will spend the next two years researching whether an enzyme found in MRSA bacteria from the 1950s could help solve today’s problem of antibiotic tolerance.
Research project reaches major milestone in NHS to protect babies from...
More than 1,100 pregnant women in North East UK have taken part in a rapid beside test to protect newborns from life-threatening illnesses which can be passed onto babies during birth.
Hope for long-term antidepressant users as study shows half can come...
Nearly half of long-term antidepressant users can quit the drugs with GP support and access to internet or telephone helplines alone, a study has revealed.
Novel Bristol therapeutic to target atheroschlerosis
Scientists at the University of Bristol have uncovered a new disease driving mechanism which they are aiming to target to help treat the development of atherosclerotic plaques.
Nature time boosts children’s mental health, especially for those from low-income...
Children who spend more time in natural environments have significantly better mental health, according to new research led by the University of Glasgow.
Study exposes gaps in menstrual health education in English schools
A new study reveals inadequacies in menstrual health education provision in English schools. Findings highlight a lack of practical information being offered, pupils being taught too late...
Inspirational figures to be honoured by Durham University
Inspirational figures from the worlds of human rights, education, media, conservation and business are to be honoured by Durham University.